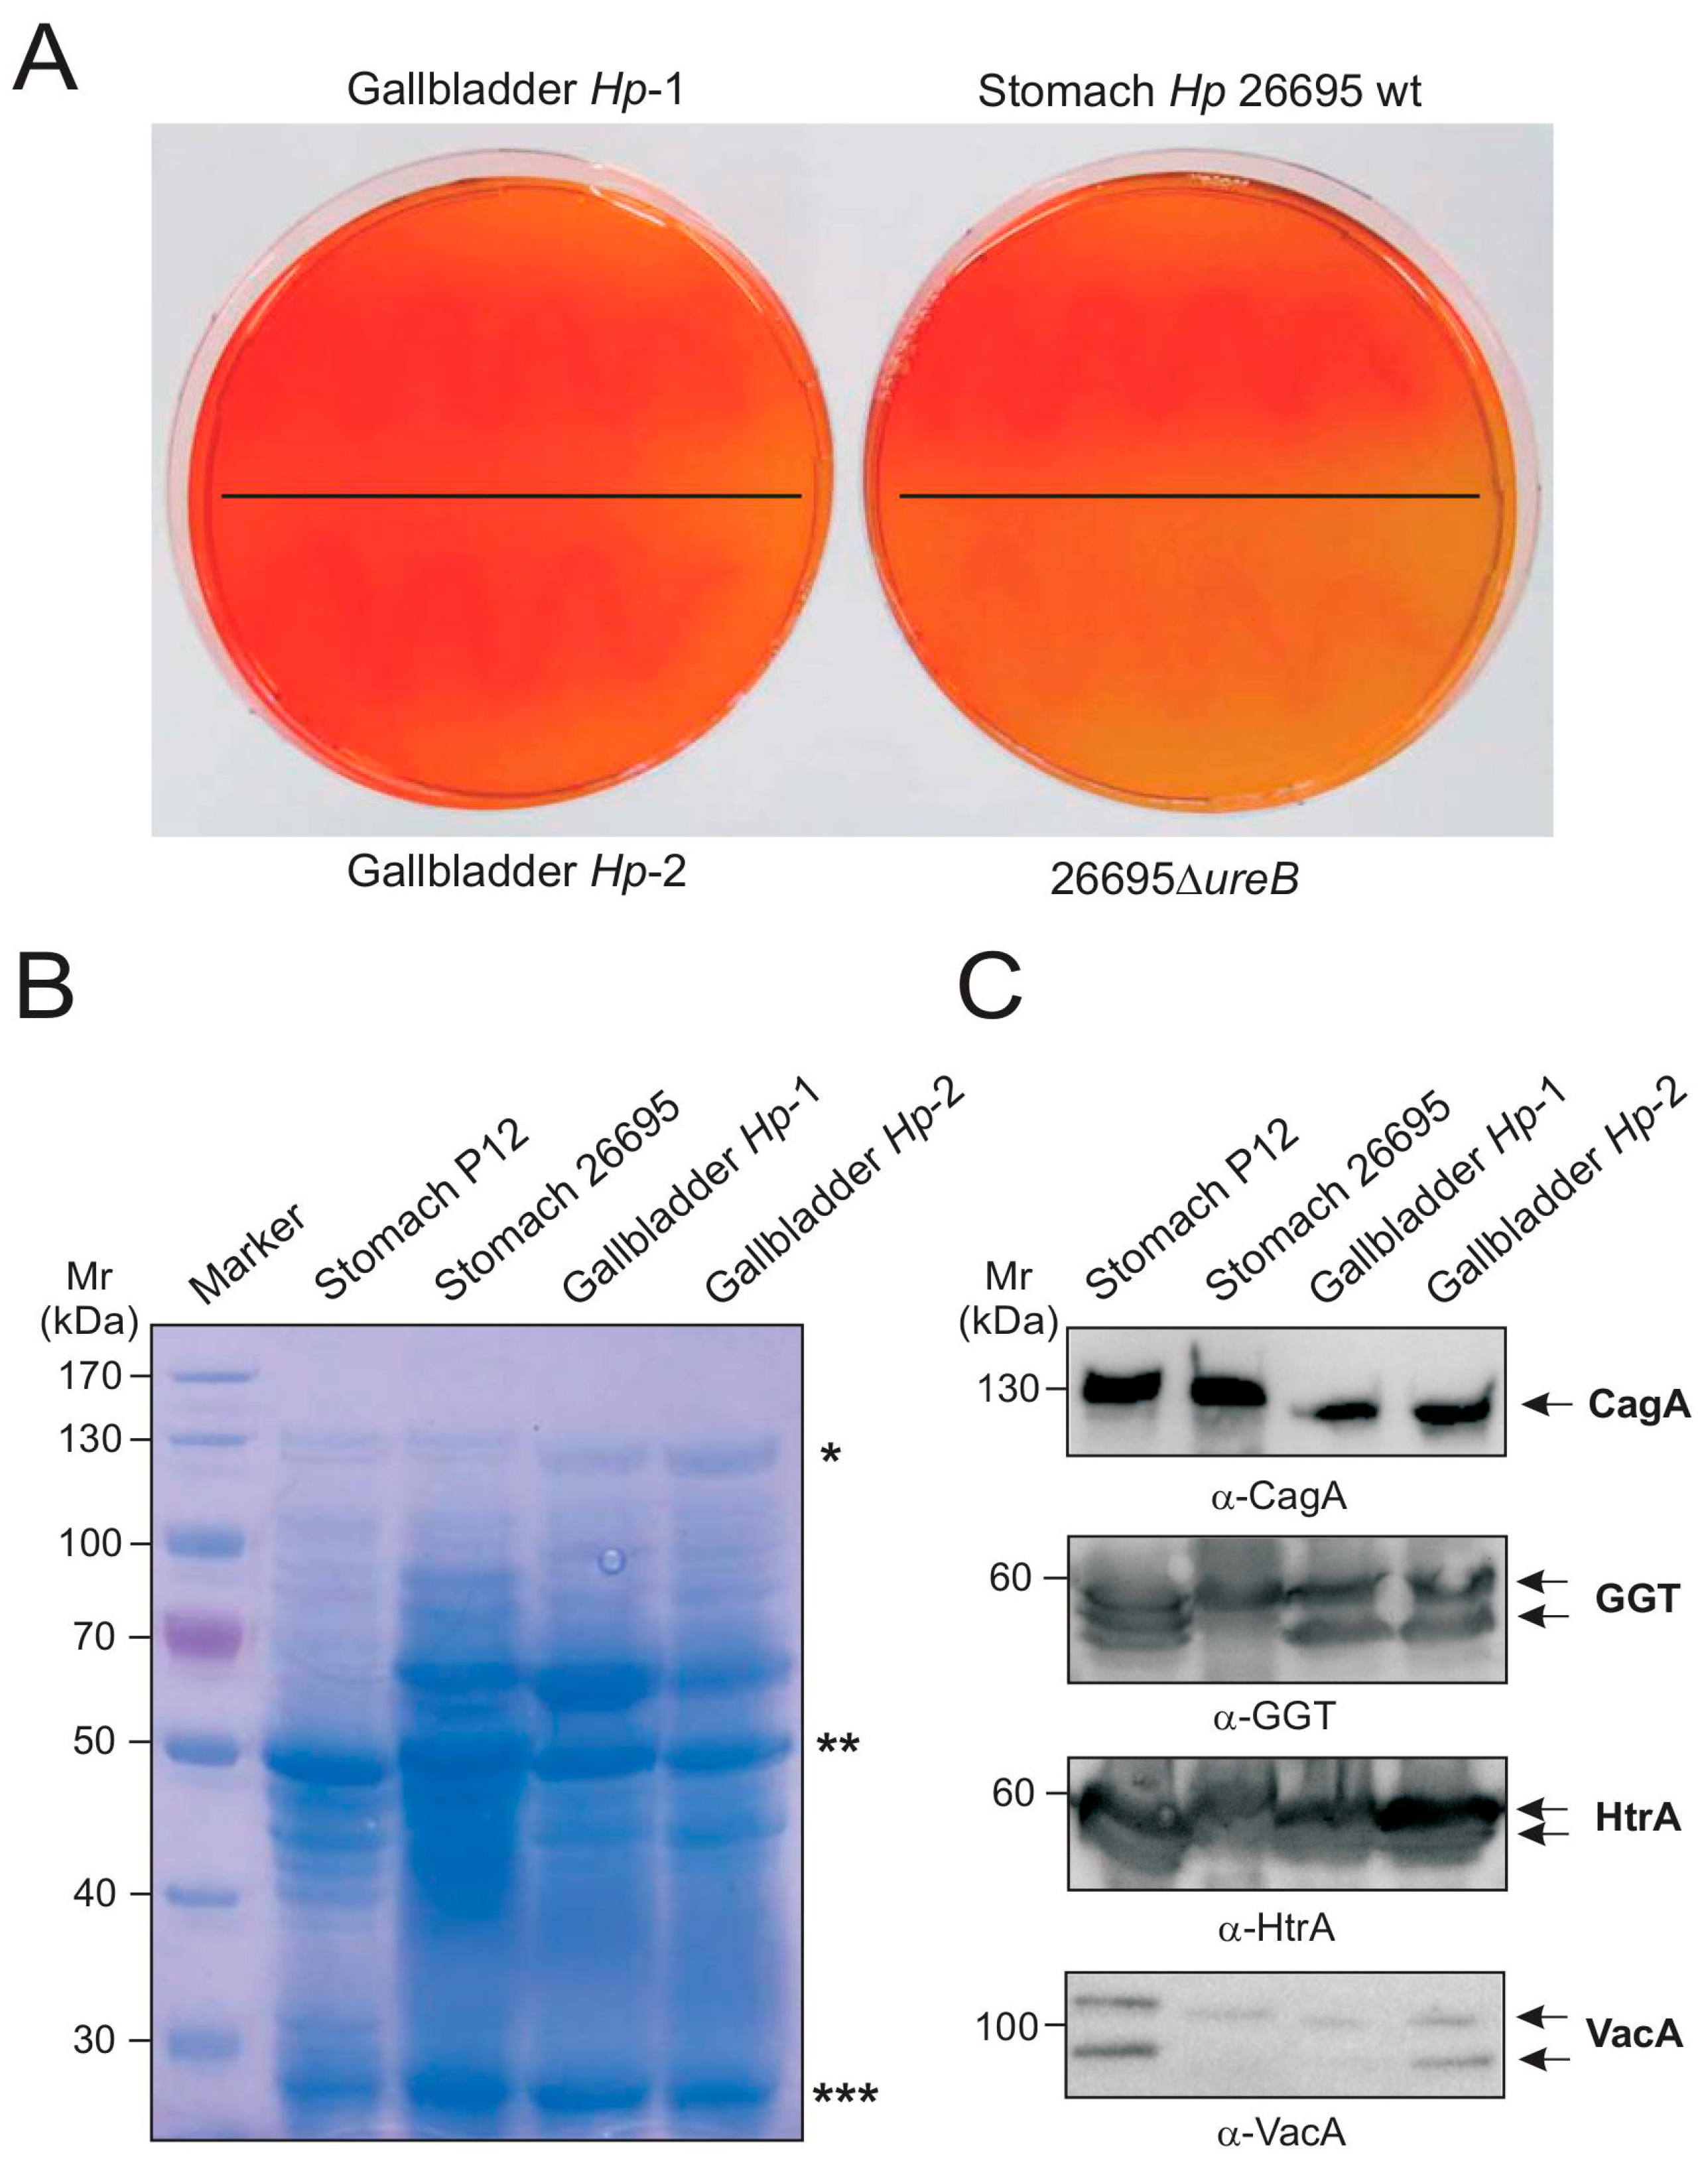
Ijms 19 01826 g003

Unusual Manifestation of Live Staphylococcus saprophyticus, Corynebacterium urinapleomorphum, and Helicobacter pylori in the Gallbladder with Cholecystitis
Abstract
:1. Introduction
2. Results
2.1. Case Presentation
2.2. Identification of Live Bacteria in the Gallbladder
2.3. Microscopic Examination of Gallbladder Bacteria
2.4. Biochemical Characterization of Gallbladder H. pylori
2.5. Genetic Comparison of Stomach and Gallbladder H. pylori
3. Discussion
4. Materials and Methods
4.1. Ethics Statement, Biopsy Preparation, and Immunohistochemistry
4.2. Bacterial Isolation
4.3. Bacterial Gram-Staining
4.4. Bacterial Urease Test
4.5. DNA Isolation and 16S rRNA Gene Analysis
4.6. Protein Profiling
4.7. Western Blotting and Antibodies
4.8. Field Emission Scanning Electron Microscopy
4.9. RAPD Fingerprinting
4.10. CagA Gene PCR and Sequencing
Author Contributions
Funding
Acknowledgments
Conflicts of Interest
References
- Ruiz-Rebollo, M.L.; Sánchez-Antolín, G.; García-Pajares, F.; Vallecillo-Sande, M.A.; Fernández-Orcajo, P.; Velicia-Llames, R.; Caro-Patón, A. Acalculous cholecystitis due to Salmonella enteritidis. World J. Gastroenterol. 2008, 14, 6408–6409. [Google Scholar] [CrossRef] [PubMed]
- Zhou, D.; Guan, W.B.; Wang, J.D.; Zhang, Y.; Gong, W.; Quan, Z.W. A comparative study of clinicopathological features between chronic cholecystitis patients with and without Helicobacter pylori infection in gallbladder mucosa. PLoS ONE 2013, 8, e70265. [Google Scholar] [CrossRef] [PubMed]
- Liu, J.; Yan, Q.; Luo, F.; Shang, D.; Wu, D.; Zhang, H.; Shang, X.; Kang, X.; Abdo, M.; Liu, B.; et al. Acute cholecystitis associated with infection of Enterobacteriaceae from gut microbiota. Clin. Microbiol. Infect. 2015, 21, 851.e1–851.e9. [Google Scholar] [CrossRef] [PubMed]
- Gunn, J.S.; Marshall, J.M.; Baker, S.; Dongol, S.; Charles, R.C.; Ryan, E.T. Salmonella chronic carriage: Epidemiology, diagnosis, and gallbladder persistence. Trends Microbiol. 2014, 22, 648–655. [Google Scholar] [CrossRef] [PubMed]
- Tajeddin, E.; Sherafat, S.J.; Majidi, M.R.; Alebouyeh, M.; Alizadeh, A.H.; Zali, M.R. Association of diverse bacterial communities in human bile samples with biliary tract disorders: A survey using culture and polymerase chain reaction-denaturing gradient gel electrophoresis methods. Eur. J. Clin. Microbiol. Infect. Dis. 2016, 35, 1331–1339. [Google Scholar] [CrossRef] [PubMed]
- Kawaguchi, M.; Saito, T.; Ohno, H.; Midorikawa, S.; Sanji, T.; Handa, Y.; Morita, S.; Yoshida, H.; Tsurui, M.; Misaka, R.; et al. Bacteria closely resembling Helicobacter pylori detected immunohistologically and genetically in resected gallbladder mucosa. J. Gastroenterol. 1996, 31, 294–298. [Google Scholar] [CrossRef] [PubMed]
- Chen, D.F.; Hu, L.; Yi, P.; Liu, W.W.; Fang, D.C.; Cao, H.H. H. pylori exist in the gallbladder mucosa of patients with chronic cholecystitis. World J. Gastroenterol. 2007, 13, 1608–1611. [Google Scholar] [CrossRef] [PubMed]
- Bansal, V.K.; Misra, M.C.; Chaubal, G.; Datta Gupta, S.; Das, B.; Ahuja, V.; Sagar, S. Helicobacter pylori in gallbladder mucosa in patients with gallbladder disease. Indian J. Gastroenterol. 2012, 31, 57–60. [Google Scholar] [CrossRef] [PubMed]
- Backert, S.; Clyne, M. Pathogenesis of Helicobacter pylori infection. Helicobacter 2011, 16 (Suppl. 1), 19–25. [Google Scholar] [CrossRef] [PubMed]
- Moese, S.; Selbach, M.; Brinkmann, V.; Karlas, A.; Haimovich, B.; Backert, S.; Meyer, T.F. The Helicobacter pylori CagA protein disrupts matrix adhesion of gastric epithelial cells by dephosphorylation of vinculin. Cell. Microbiol. 2007, 9, 1148–1161. [Google Scholar] [CrossRef] [PubMed]
- Brisslert, M.; Enarsson, K.; Lundin, S.; Karlsson, A.; Kusters, J.G.; Svennerholm, A.M.; Backert, S.; Quiding-Järbrink, M. Helicobacter pylori induce neutrophil transendothelial migration: Role of the bacterial HP-NAP. FEMS Microbiol. Lett. 2005, 249, 95–103. [Google Scholar] [CrossRef] [PubMed]
- Länderarbeitsgemeinschaft Gentechnik (LAG), Method Number: AM020. Available online: http://www.lag-gentechnik.de/dokumente/uam-methoden/020.pdf (accessed on 16 February 2017).
- Traverso, F.R.; Bohr, U.R.; Oyarzabal, O.A.; Rohde, M.; Clarici, A.; Wex, T.; Kuester, D.; Malfertheiner, P.; Fox, J.G.; Backert, S. Morphologic, genetic, and biochemical characterization of Helicobacter magdeburgensis, a novel species isolated from the intestine of laboratory mice. Helicobacter 2010, 15, 403–415. [Google Scholar] [CrossRef] [PubMed]
- Kumar, S.; Stecher, G.; Tamura, K. MEGA7: Molecular Evolutionary Genetics Analysis version 7.0 for bigger datasets. Mol. Biol. Evol. 2016, 33, 1870–1874. [Google Scholar] [CrossRef] [PubMed] [Green Version]
- Sneath, P.H.A.; Sokal, R.R. Numerical Taxonomy; Freeman: San Francisco, CA, USA, 1973. [Google Scholar]
- Tamura, K.; Nei, M.; Kumar, S. Prospects for inferring very large phylogenies by using the neighbor-joining method. Proc. Natl. Acad. Sci. USA 2004, 101, 11030–11035. [Google Scholar] [CrossRef] [PubMed] [Green Version]
- Schoep, T.D.; Fulurija, A.; Good, F.; Lu, W.; Himbeck, R.P.; Schwan, C.; Choi, S.S.; Berg, D.E.; Mittl, P.R.; Benghezal, M.; et al. Surface properties of Helicobacter pylori urease complex are essential for persistence. PLoS ONE 2010, 5, e15042. [Google Scholar] [CrossRef] [PubMed] [Green Version]
- Koch, K.N.; Hartung, M.L.; Urban, S.; Kyburz, A.; Bahlmann, A.S.; Lind, J.; Backert, S.; Taube, C.; Müller, A. Helicobacter urease-induced activation of the TLR2/NLRP3/IL-18 axis protects against asthma. J. Clin. Investig. 2015, 125, 3297–3302. [Google Scholar] [CrossRef] [PubMed]
- Moese, S.; Selbach, M.; Zimny-Arndt, U.; Jungblut, P.R.; Meyer, T.F.; Backert, S. Identification of a tyrosine-phosphorylated 35 kDa carboxy-terminal fragment (p35CagA) of the Helicobacter pylori CagA protein in phagocytic cells: Processing or breakage? Proteomics 2001, 1, 618–629. [Google Scholar] [CrossRef]
- Tomb, J.F.; White, O.; Kerlavage, A.R.; Clayton, R.A.; Sutton, G.G.; Fleischmann, R.D.; Ketchum, K.A.; Klenk, H.P.; Gill, S.; Dougherty, B.A.; et al. The complete genome sequence of the gastric pathogen Helicobacter pylori. Nature 1997, 388, 539–547. [Google Scholar] [CrossRef] [PubMed]
- Pachathundikandi, S.K.; Tegtmeyer, N.; Backert, S. Signal transduction of Helicobacter pylori during interaction with host cell protein receptors of epithelial and immune cells. Gut Microbes 2013, 4, 454–474. [Google Scholar] [CrossRef] [PubMed]
- Tegtmeyer, N.; Rivas Traverso, F.; Rohde, M.; Oyarzabal, O.A.; Lehn, N.; Schneider-Brachert, W.; Ferrero, R.L.; Fox, J.G.; Berg, D.E.; Backert, S.; et al. Electron microscopic, genetic and protein expression analyses of Helicobacter acinonychis strains from a Bengal tiger. PLoS ONE 2013, 8, e71220. [Google Scholar] [CrossRef] [PubMed] [Green Version]
- Tegtmeyer, N.; Wessler, S.; Necchi, V.; Rohde, M.; Harrer, A.; Rau, T.T.; Asche, C.I.; Boehm, M.; Loessner, H.; Figueiredo, C.; et al. A unique basolateral type IV secretion model for the CagA oncoprotein of Helicobacter pylori. Cell Host Microbe 2017, 22, 552–560. [Google Scholar] [CrossRef] [PubMed]
- Kwok, T.; Zabler, D.; Urman, S.; Rohde, M.; Hartig, R.; Wessler, S.; Misselwitz, R.; Berger, J.; Sewald, N.; König, W.; et al. Helicobacter exploits integrin for type IV secretion and kinase activation. Nature 2007, 449, 862–866. [Google Scholar] [CrossRef] [PubMed]
- Backert, S.; Kwok, T.; König, W. Conjugative plasmid DNA transfer in Helicobacter pylori mediated by chromosomally encoded relaxase and TraG-like proteins. Microbiology 2005, 151, 3493–3503. [Google Scholar] [CrossRef] [PubMed]
- Oyarzabal, O.A.; Rad, R.; Backert, S. Conjugative transfer of chromosomally encoded antibiotic resistance from Helicobacter pylori to Campylobacter jejuni. J. Clin. Microbiol. 2007, 45, 402–408. [Google Scholar] [CrossRef] [PubMed]
- Akopyanz, N.; Bukanov, N.O.; Westblom, T.U.; Kresovich, S.; Berg, D.E. DNA diversity among clinical isolates of Helicobacter pylori detected by PCR-based RAPD fingerprinting. Nucleic Acids Res. 1992, 20, 5137–5142. [Google Scholar] [CrossRef] [PubMed]
- Kumar, S.; Kumar, S.; Kumar, S. Infection as a risk factor for gallbladder cancer. J. Surg. Oncol. 2006, 93, 633–639. [Google Scholar] [CrossRef] [PubMed]
- Maurer, K.J.; Carey, M.C.; Fox, J.G. Roles of infection, inflammation, and the immune system in cholesterol gallstone formation. Gastroenterology 2009, 136, 425–440. [Google Scholar] [CrossRef] [PubMed]
- Julka, K.; Ko, C.W. Infectious diseases and the gallbladder. Infect. Dis. Clin. N. Am. 2010, 24, 885–898. [Google Scholar] [CrossRef] [PubMed]
- Raz, R.; Colodner, R.; Kunin, C.M. Who Are You—Staphylococcus saprophyticus? Clin. Infect. Dis. 2005, 40, 896–898. [Google Scholar] [CrossRef] [PubMed]
- Widerström, M.; Wiström, J.; Sjöstedt, A.; Monsen, T. Coagulase-negative staphylococci: Update on the molecular epidemiology and clinical presentation, with a focus on Staphylococcus epidermidis and Staphylococcus saprophyticus. Eur. J. Clin. Microbiol. Infect. Dis. 2012, 31, 7–20. [Google Scholar] [CrossRef] [PubMed]
- Morand, A.; Chabrol, B.; Cadoret, F.; Fournier, P.E.; Raoult, D. “Corynebacterium urinapleomorphum” sp. nov.; isolated from a urine sample of a 2-month-old boy affected by rotavirus gastroenteritis. New Microbes New Infect. 2016, 15, 21–23. [Google Scholar] [CrossRef] [PubMed]
- Naumann, M.; Sokolova, O.; Tegtmeyer, N.; Backert, S. Helicobacter pylori: A Paradigm Pathogen for Subverting Host Cell Signal Transmission. Trends Microbiol. 2017, 25, 316–328. [Google Scholar] [CrossRef] [PubMed]
- Kivi, M.; Tindberg, Y. Helicobacterpylori occurrence and transmission: A family affair? Scand. J. Infect. Dis. 2006, 38, 407–417. [Google Scholar] [CrossRef] [PubMed]
- Hirsch, C.; Tegtmeyer, N.; Rohde, M.; Rowland, M.; Oyarzabal, O.A.; Backert, S. Live Helicobacter pylori in the root canal of endodontic-infected deciduous teeth. J. Gastroenterol. 2012, 47, 936–940. [Google Scholar] [CrossRef] [PubMed]
- Kwok, T.; Backert, S.; Schwarz, H.; Berger, J.; Meyer, T.F. Specific entry of Helicobacter pylori into cultured gastric epithelial cells via a zipper-like mechanism. Infect. Immun. 2002, 70, 2108–2120. [Google Scholar] [CrossRef] [PubMed]
- Lind, J.; Backert, S.; Pfleiderer, K.; Berg, D.E.; Yamaoka, Y.; Sticht, H.; Tegtmeyer, N. Systematic analysis of phosphotyrosine antibodies recognizing single phosphorylated EPIYA-motifs in CagA of Western-type Helicobacter pylori strains. PLoS ONE 2014, 9, e96488. [Google Scholar] [CrossRef] [PubMed]
- Lind, J.; Backert, S.; Hoffmann, R.; Eichler, J.; Yamaoka, Y.; Perez-Perez, G.I.; Torres, J.; Sticht, H.; Tegtmeyer, N. Systematic analysis of phosphotyrosine antibodies recognizing single phosphorylated EPIYA-motifs in CagA of East Asian-type Helicobacter pylori strains. BMC Microbiol. 2016, 16, 201. [Google Scholar] [CrossRef] [PubMed]
- Javaheri, A.; Kruse, T.; Moonens, K.; Mejías-Luque, R.; Debraekeleer, A.; Asche, C.I.; Tegtmeyer, N.; Kalali, B.; Bach, N.C.; Sieber, S.A.; et al. Helicobacter pylori adhesin HopQ engages in a virulence-enhancing interaction with human CEACAMs. Nat. Microbiol. 2016, 2, 16189. [Google Scholar] [CrossRef] [PubMed]
- Kumar Pachathundikandi, S.; Brandt, S.; Madassery, J.; Backert, S. Induction of TLR-2 and TLR-5 expression by Helicobacter pylori switches cagPAI-dependent signalling leading to the secretion of IL-8 and TNF-α. PLoS ONE 2011, 6, e19614. [Google Scholar] [CrossRef] [PubMed]
- Conradi, J.; Tegtmeyer, N.; Woźna, M.; Wissbrock, M.; Michalek, C.; Gagell, C.; Cover, T.L.; Frank, R.; Sewald, N.; Backert, S. An RGD helper sequence in CagL of Helicobacter pylori assists in interactions with integrins and injection of CagA. Front. Cell. Infect. Microbiol. 2012, 2, 70. [Google Scholar] [CrossRef] [PubMed] [Green Version]
- Zhang, Z.; Schwartz, S.; Wagner, L.; Miller, W.J. A greedy algorithm for aligning DNA sequences. Comput. Biol. 2000, 7, 203–214. [Google Scholar] [CrossRef] [PubMed]
- Megraud, F.; Bonnet, F.; Garnier, M.; Lamouliatte, H. Characterization of “Campylobacter pyloridis” by culture, enzymatic profile, and protein content. J. Clin. Microbiol. 1985, 22, 1007–1010. [Google Scholar] [PubMed]
- Backert, S.; Müller, E.C.; Jungblut, P.R.; Meyer, T.F. Tyrosine phosphorylation patterns and size modification of the Helicobacter pylori CagA protein after translocation into gastric epithelial cells. Proteomics 2001, 1, 608–617. [Google Scholar] [CrossRef]
- Albrecht, N.; Tegtmeyer, N.; Sticht, H.; Skórko-Glonek, J.; Backert, S. Amino-Terminal Processing of Helicobacter pylori Serine Protease HtrA: Role in Oligomerization and Activity Regulation. Front. Microbiol. 2018, 9, 642. [Google Scholar] [CrossRef] [PubMed]
- Sason, H.; Milgrom, M.; Weiss, A.M.; Melamed-Book, N.; Balla, T.; Grinstein, S.; Backert, S.; Rosenshine, I.; Aroeti, B. Enteropathogenic Escherichia coli subverts phosphatidylinositol 4,5-bisphosphate and phosphatidylinositol 3,4,5-trisphosphate upon epithelial cell infection. Mol. Biol. Cell 2009, 20, 544–555. [Google Scholar] [CrossRef] [PubMed]
- Harrer, A.; Boehm, M.; Backert, S.; Tegtmeyer, N. Overexpression of serine protease HtrA enhances disruption of adherens junctions, paracellular transmigration and type IV secretion of CagA by Helicobacter pylori. Gut Pathog. 2017, 9, 40. [Google Scholar] [CrossRef] [PubMed]
- Boehm, M.; Krause-Gruszczynska, M.; Rohde, M.; Tegtmeyer, N.; Takahashi, S.; Oyarzabal, O.A.; Backert, S. Major host factors involved in epithelial cell invasion of Campylobacter jejuni: Role of fibronectin, integrin beta1, FAK, Tiam-1, and DOCK180 in activating Rho GTPase Rac1. Front. Cell. Infect. Microbiol. 2011, 1, 17. [Google Scholar] [CrossRef] [PubMed]
- Krause-Gruszczynska, M.; Boehm, M.; Rohde, M.; Tegtmeyer, N.; Takahashi, S.; Buday, L.; Oyarzabal, O.A.; Backert, S. The signaling pathway of Campylobacter jejuni-induced Cdc42 activation: Role of fibronectin, integrin beta1, tyrosine kinases and guanine exchange factor Vav2. Cell Commun. Signal. 2011, 9, 32. [Google Scholar] [CrossRef] [PubMed]

© 2018 by the authors. Licensee MDPI, Basel, Switzerland. This article is an open access article distributed under the terms and conditions of the Creative Commons Attribution (CC BY) license (http://creativecommons.org/licenses/by/4.0/).
Share and Cite
Backert, S.; Tegtmeyer, N.; Oyarzabal, O.A.; Osman, D.; Rohde, M.; Grützmann, R.; Vieth, M. Unusual Manifestation of Live Staphylococcus saprophyticus, Corynebacterium urinapleomorphum, and Helicobacter pylori in the Gallbladder with Cholecystitis. Int. J. Mol. Sci. 2018, 19, 1826. https://doi.org/10.3390/ijms19071826
Backert S, Tegtmeyer N, Oyarzabal OA, Osman D, Rohde M, Grützmann R, Vieth M. Unusual Manifestation of Live Staphylococcus saprophyticus, Corynebacterium urinapleomorphum, and Helicobacter pylori in the Gallbladder with Cholecystitis. International Journal of Molecular Sciences. 2018; 19(7):1826. https://doi.org/10.3390/ijms19071826
Chicago/Turabian StyleBackert, Steffen, Nicole Tegtmeyer, Omar A. Oyarzabal, Dana Osman, Manfred Rohde, Robert Grützmann, and Michael Vieth. 2018. "Unusual Manifestation of Live Staphylococcus saprophyticus, Corynebacterium urinapleomorphum, and Helicobacter pylori in the Gallbladder with Cholecystitis" International Journal of Molecular Sciences 19, no. 7: 1826. https://doi.org/10.3390/ijms19071826





